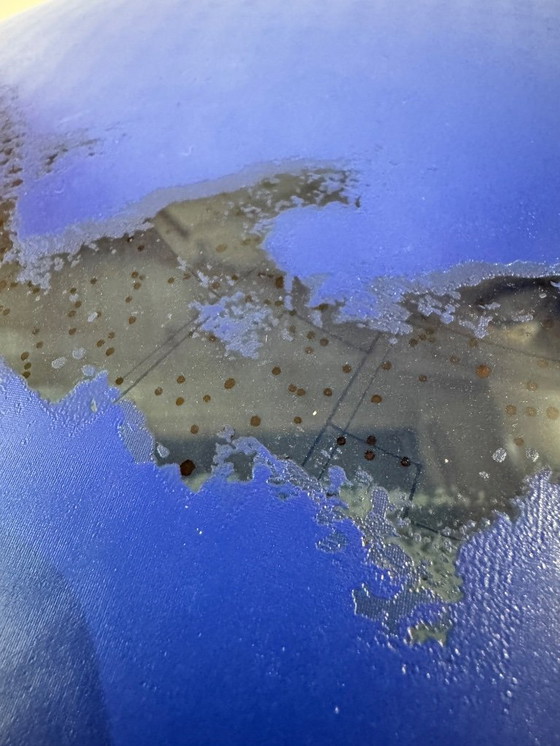
Image 1 of Blaue Design-Schale mit Sternen nördliche Hemisphäre

Sorgenfreie LieferungKäuferschutzAlle Designerartikel kuratiert von WhoppahLade die Whoppah-App herunter. Immer auf dem Laufenden.

Blaue Design-Schale mit Sternen nördliche Hemisphäre
200 €150 €-25%
Einkaufen bei Whoppah
Sicher einkaufen & bezahlen mit KäuferschutzAlle Designerartikel sind 100% authentischWir zahlen den Verkäufer erst aus, wenn du den Artikel einwandfrei erhalten hastSichere Zahlungsmethoden
Über diesen Verkäufer
Privater VerkäuferBeschreibung des Produkts
Schöne blaue Glasschale. Die Schale besteht aus einer Glasplatte und ist auf der Unterseite mit blauem Lack überzogen. Die Glasplatte hat die nördliche Hemisphäre Galaxie auf der Oberseite eingraviert. Gekauft in dem Geschäft City of Glass. Dieses Designgeschäft befand sich 1993 in der Nähe der Kathedrale. Wen kann ich damit glücklich machen?
Spezifikationen
ZustandAusgezeichnetFarbenBlauMaterialGlasAnzahl der Artikel1Erster EigentümerJaHöhe7 cmBreite35 cm
Entdecken Sie mehr
Verkäuferinformationen
Über diesen Verkäufer
Privater VerkäuferHouten, NiederlandeBei Whoppah seit Juni 2025 • 0 Verkäufe